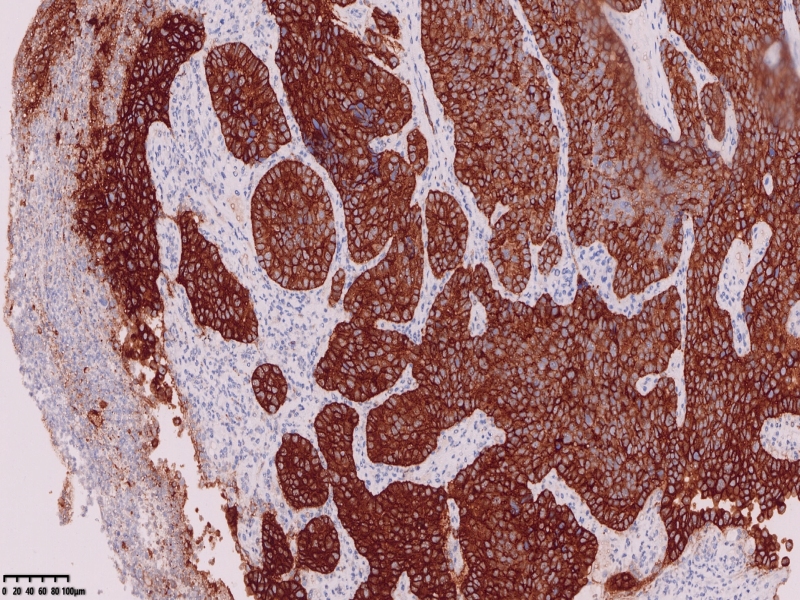

我的博文
食管-贲门-胃体肿物。
2025-10-18 08:52
阅读(46)
评论(0)
分类:胃
患者男73岁254788
胃镜诊断:食管-贲门-胃体肿物。
胃镜可见距离门齿35厘米一下可见一肿物凸向管腔,向下延伸至贲门口、胃体上部,管腔狭窄,胃镜勉强通过,肿物中央城溃疡状,覆盖白苔,周围坎坝杨改变,活检8块。
镜下所见:胃粘膜组织数块,炎症背景,其中3块固有层内可见细胞团,瘤细胞排列呈条索状迂回后呈巢状,巢的边缘瘤细胞呈栅栏状。细胞形态似柱状。
第一感觉考虑神经内分泌肿瘤?会诊考虑低分化腺癌。以前也遇到一个类似病例,贲门口占位,初步考虑神经内分泌肿瘤,但是神经内分泌标记均为阴性,最后考虑低分化腺癌。
免疫组化:ki67增值指数较高约80%,CK7VillinCAM5.2、CEA+,CA19-9CDX-2部分+
神经内分泌标记S100-,只做了这一个
错配修复蛋白均+








 KI67
KI67

CK7
 CEA
CEA
CA19-9
CA19-9
 CAM5.2
CAM5.2
 P53
P53

本文允许在互联网范围内转载,使用时请注明作者姓名、作品名称及作品来源。
我要评论




共0条评论